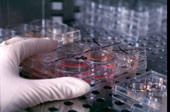

В российское общество клонов не допустят
Комитет Госдумы на заседании в среду поддержал правительственный законопроект о продлении до 2012 года запрета на клонирование человека и предложил палате рассмотреть его в первом чтении 22 января, передает РИА Новости. Документ поддержан Российской академией наук и Российской академией медицинских наук. Как ранее сообщила глава Минздравсоцразвития Татьяна Голикова, мораторий на клонирование закончился 23 июня 2007 года, а сам закон был принят в 2002 году. В соответствии с декларацией ООН о клонировании человека было принято решение продлить мораторий на пять лет. Декларация ООН о клонировании человека призывает к запрету всех форм клонирования людей в той мере, в какой они несовместимы с человеческим достоинством и защитой человеческой жизни.
Клонирование до сих пор является предметом серьезной дискуссии в обществе с точки зрения этики. Технология клонирования человека пока окончательно не разработана, а его сторонники сталкиваются со множеством юридических, этических и религиозных проблем.
Стоит отметить, что летом прошлого года в Кемеровской области открылась лаборатория по клонированию, она же - спеццентр по тканевой инженерии на основе нанотехнологий. Научный экспериментальный комплекс расположился на базе Кузбасского кардиоцентра, расположенном в Кемерове. На строительство и оснащение лаборатории было выделено 160 млн рублей, две трети - федеральные средства, треть - региональные. В лаборатории будут работать медики, биологи, биохимики - в их распоряжении лучшее оборудование для генетических исследований, моделирования биопротезов сердца и сосудов, разработки уникальных лекарственных препаратов.
Напомним, что год назад скандально известный итальянский врач Северино Антинори (Severino Antinori) заявил, что девять лет назад осуществил клонирование человека. "Я способствовал рождению трех детей при помощи техники человеческого клонирования. Они - два мальчика и одна девочка - выросли и сейчас им по 9 лет. На данный момент у них отличное здоровье", - сказал он. Антинори не предъявил никаких доказательств сделанного им, однако отметил, что подобная процедура была выполнена с применением клеток, взятых у трех стерильных отцов, и пересаженных трем женщинам. По его словам, этот метод похож на операцию, которая была проведена для клонирования знаменитой овечки Долли в 1996 году.
Антинори стал широко известен в Италии в связи с его работой над техникой, позволяющей женщинам забеременеть после наступления менопаузы.
Помимо этого, последняя громкая история, связанная с именем врача, касается желания 40-летней жительницы северного итальянского города Виджевано (Vigevano) зачать ребенка от своего 35-летнего супруга, находящегося в коме. Антинори выразил готовность помочь ей.
Кроме этого, весной прошлого года, члены Европарламента проголосовали "широким большинством голосов" против клонирования животных в продовольственных целях. На сегодняшний день нигде в мире продукты из мяса животных-клонов не продаются, однако, по мнению экспертов, они могут появиться на продовольственных рынках к 2010 году, в частности, в США. В марте комитет по безопасности продуктов питания при правительстве Японии сделал заключение о том, что мясо клонированных коров и свиней безопасно.
Европейское агентство по продовольственной безопасности (EFSA) в январе прошлого года обнародовало предварительное заключение, согласно которому, мясо и молоко клонированных животных пригодно в пищу. Эксперты EFSA, проводившие исследование по поручению Еврокомиссии, считают "очень маловероятным, что существует какое-либо отличие в плане продовольственной безопасности" между мясом и молоком животных-клонов и их сородичей, выращенных традиционным путем.
В свою очередь, эксперты японского правительства пришли к выводу, что мясо клонированных коров и свиней полностью пригодно к употреблению в пищу и может поступить в широкую продажу.
Подписывайтесь на NewsInfo.Ru